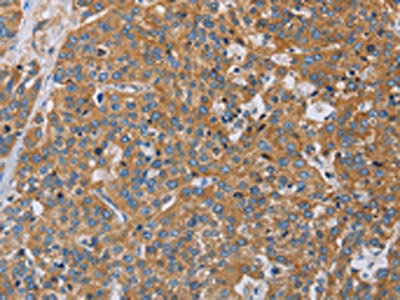

ACTN4 Antibody
-
中文名稱:ACTN4兔多克隆抗體
-
貨號:CSB-PA070925
-
規格:¥1100
-
圖片:
-
The image on the left is immunohistochemistry of paraffin-embedded Human esophagus cancer tissue using CSB-PA070925(ACTN4 Antibody) at dilution 1/60, on the right is treated with fusion protein. (Original magnification: ×200)
-
The image on the left is immunohistochemistry of paraffin-embedded Human thyroid cancer tissue using CSB-PA070925(ACTN4 Antibody) at dilution 1/60, on the right is treated with fusion protein. (Original magnification: ×200)
-
Gel: 6%SDS-PAGE, Lysate: 40 μg, Lane 1-4: Lovo cells, mouse kidney tissue, 231 cells, hepG2 cells, Primary antibody: CSB-PA070925(ACTN4 Antibody) at dilution 1/485, Secondary antibody: Goat anti rabbit IgG at 1/8000 dilution, Exposure time: 10 seconds
-
-
其他:
產品詳情
-
Uniprot No.:
-
基因名:
-
別名:actinin 4 antibody; Actinin alpha 4 antibody; actinin4 antibody; ACTN 4 antibody; ACTN4 antibody; ACTN4_HUMAN antibody; Alpha-actinin-4 antibody; DKFZp686K23158 antibody; F actin cross linking protein antibody; F-actin cross-linking protein antibody; Focal segmental glomerulosclerosis 1 antibody; FSGS 1 antibody; FSGS antibody; FSGS1 antibody; Non muscle alpha actinin 4 antibody; Non-muscle alpha-actinin 4 antibody
-
宿主:Rabbit
-
反應種屬:Human,Mouse,Rat
-
免疫原:Fusion protein of Human ACTN4
-
免疫原種屬:Homo sapiens (Human)
-
標記方式:Non-conjugated
-
抗體亞型:IgG
-
純化方式:Antigen affinity purification
-
濃度:It differs from different batches. Please contact us to confirm it.
-
保存緩沖液:-20°C, pH7.4 PBS, 0.05% NaN3, 40% Glycerol
-
產品提供形式:Liquid
-
應用范圍:ELISA,WB,IHC
-
推薦稀釋比:
Application Recommended Dilution ELISA 1:2000-1:5000 WB 1:500-1:2000 IHC 1:50-1:200 -
Protocols:
-
儲存條件:Upon receipt, store at -20°C or -80°C. Avoid repeated freeze.
-
貨期:Basically, we can dispatch the products out in 1-3 working days after receiving your orders. Delivery time maybe differs from different purchasing way or location, please kindly consult your local distributors for specific delivery time.
-
用途:For Research Use Only. Not for use in diagnostic or therapeutic procedures.
相關產品
靶點詳情
-
功能:F-actin cross-linking protein which is thought to anchor actin to a variety of intracellular structures. This is a bundling protein. Probably involved in vesicular trafficking via its association with the CART complex. The CART complex is necessary for efficient transferrin receptor recycling but not for EGFR degradation. Involved in tight junction assembly in epithelial cells probably through interaction with MICALL2. Links MICALL2 to the actin cytoskeleton and recruits it to the tight junctions. May also function as a transcriptional coactivator, stimulating transcription mediated by the nuclear hormone receptors PPARG and RARA.
-
基因功能參考文獻:
- we summarize current knowledge regarding therapeutic strategies for locally advanced pancreatic cancer and discuss the potential development of personalized medicine using ACTN4 measurement for patients with locally advanced pancreatic cancer--{REVIEW} PMID: 29921500
- Actinin-4 directly binds to the cytosolic tail of CD147 and governs the assembly of CD147-beta2-adrenergic receptor complexes in highly ordered clusters at bacterial adhesion sites.Actinin-4 is recruited to bacterial adhesion sites. PMID: 28569760
- significantly upregulated in the cervical mucus of women with preterm labor with microbial invasion of the amniotic cavity PMID: 28743114
- Data suggest that TYRO3-mediated phosphorylation of ACTN4 is involved in invasiveness of melanoma cells; TYRO3-mediated phosphorylation of ACTN4 requires FAK activation at tyrosine 397. (TYRO3 = TYRO3 protein tyrosine kinase; ACTN4 = actinin alpha 4; FAK = focal adhesion kinase isoform FAK1) PMID: 29274473
- ACTN4 knockdown resulted in the blockage of malignant cell proliferation, colony formation, and ameliorated metastasis potency. ACTN4-positive CSCs exhibited a higher ESA(+) proportion, increased mammosphere-formation ability, and enhanced in vivo tumorigenesis ability. PMID: 29197410
- These results demonstrate that both actinin-1 and actinin-4 participate in the assembly of F-actin at invadopodia. Additionally, actinin-4 may have a selective advantage in accelerating invadopodia-mediated invasion of carcinoma cells. PMID: 28797528
- Gene amplification of ACTN4 was a significant independent risk factor for death in patients with stage I/II oral tongue cancer (hazard ratio 6.08, 95% confidence interval 1.66-22.27). Gene amplification of ACTN4 is a potential prognostic biomarker for overall survival in oral tongue cancer. PMID: 28385383
- ACTN4 knockdown near-completely abrogates both radioresistance and epithelial-mesenchymal transition-associated changes in breast cancer cells. PMID: 29055790
- Fascin and alpha-actinin intrinsically segregate to discrete bundled domains that are specifically recognized by other actin-binding proteins. PMID: 27666967
- Suggest that ACTN4 as a potential predictive biomarker for efficacy of adjuvant chemotherapy in stage-IB/II patients with non-small cell lung cancer, by reflecting the metastatic potential of tumor cells. PMID: 27121206
- High ACTN4 expression is associated with Lung Squamous Cell Carcinoma. PMID: 27613525
- Our findings indicate that ACTN4 promotes EMT and tumorigenesis by regulating Snail expression and the Akt pathway in cervical cancer. We propose a novel mechanism for EMT and tumorigenesis in cervical cancer. PMID: 27065319
- Study found a functional Validation of an Alpha-Actinin-4 Mutation as a Potential Cause of an Aggressive Presentation of Adolescent Focal Segmental Glomerulosclerosis. PMID: 27977723
- SERPINE1, ANGPLT4, CCL20, and SAA1 as well as the NF-kappaB (p65) binding sites on GR-transrepressed promoters such as IL-1beta, IL-6, and IL-8 Taken together, our data establish ACTN4 as a transcriptional co-regulator that modulates both dexamethasone-transactivated and -transrepressed genes in podocytes. PMID: 27998979
- Here, we report the identification of a novel, disease-causing ACTN4 mutation (p.G195D, de novo) in a sporadic case of childhood FSGS using next generation sequencing. PMID: 26740551
- the calmodulin domain of human alpha-actinin-4 binding to the linker region was important for regulating the distance between actin and actin-binding domain. PMID: 27028653
- This study identified alpha-actinin-4 as a novel NHERF1 interaction partner and provided new insights into the regulatory mechanism of the actin cytoskeleton by NHERF1. PMID: 26432781
- Selective regulation of NF-kappaB gene targets may indicate involvement of ACTN4 in determining the specificity of cell response to NF-kappaB activation in cells of different types. (Review) PMID: 26995963
- ZYX defective binding to ACTN4, which occupies focal adhesions instead of ACTN1, induces the formation of immature focal adhesions, resulting in the enhancement of cell motility and invasion. PMID: 25860875
- The contribution of ACTN4 to the process of lung cancer metastasis to the brain could be mainly through regulation of actin cytoskeleton reorganization, cell motility, and focal adhesion. PMID: 25885339
- SLK interacts with Tpr and alpha-actinin-4 in cells, and these protein-protein interactions may control the subcellular localization and the biological activity of SLK. PMID: 26094769
- key regulator of endothelial cell stiffness and of ICAM-1-mediated neutrophil transmigration PMID: 25107367
- Knockdown of ACTN4 protein inhibited cell invasion and migration. These results suggest that ACTN4 is associated with lung cancer cell motility. PMID: 25299231
- alpha-actinin-4 is a novel group 1 mGluR-interacting partner that orchestrates spine dynamics and morphogenesis in neurons. PMID: 25944910
- Using fluorescence recovery after photobleaching, we show that an ACTN4 mutation that causes human kidney disease roughly triples the wild-type binding affinity of ACTN4 to F-actin in cells, increasing the dissociation time from 29 +/- 13 to 86 +/- 29 s. PMID: 25918384
- Estrogen promotes the invasion of ovarian cancer cells via activation of the PI3K/AKT pathway, downregulation of Ecadherin and upregulation of alphaactinin4. PMID: 25216292
- ACTN4va expression was also significantly related to distant metastasis PMID: 25750325
- The copy number of ACTN4 is a predictive biomarker for Chemoradiotherapy of locally advanced pancreatic cancer. PMID: 25602965
- ACTN4 is a transcriptional coactivator of NF-kappaB. PMID: 25411248
- The mRNA/protein expressions of ACTN4a was higher in the stenotic colon segment tissue than in the normal colon segment tissue of Hirschsrung disease patients. PMID: 24966941
- Findings suggest that alpha-Actinin-4 (ACTN4) plays an important role in maintaining the amoeboidal morphology of invasive melanoma and thus promoting dissemination through collagen-rich matrices. PMID: 25296750
- Copy number increase of ACTN4 is a novel indicator for an unfavorable outcome in patients with salivary gland carcinoma. PMID: 24574362
- significant correlation between actinin-4 expression and infiltrating glioma grade PMID: 23504125
- Actinin-4, a novel interacting partner of influenza A virus nucleoprotein, plays a crucial role in viral replication. PMID: 24802111
- 20 exonic and intronic substitutions were found among 48 Czech FSGS/MCD patients. 2242A>G is a candidate mutation in 1 patient. In IGA nephropathy 3 new substitutions were found: c.2351C>T, c.2378G>A and c.2393G>A. PMID: 23890478
- High ACTN4 expression is associated with thyroid cancer PMID: 24922688
- Increased expression of ACTN4 is associated with invasiveness of bladder cancer. PMID: 23817592
- Multivariate analysis revealed that ACTN4 gene amplification was the most significant independent factor associated with an extremely high risk of death among 290 patients with stage I lung adenocarcinoma. PMID: 23899839
- Data suggest that in the nucleus, ACTN4 functions as a selective transcriptional co-activator of RelA/p65. PMID: 23482348
- Mutations of TRPC6 and ACTN4 occur in only a minor portion of Chinese familial familial focal segmental glomerulosclerosis patients. PMID: 23689571
- Data suggest that ACTN4 plays roles in breast cancer tumorigenesis via promotion of cell proliferation, metastasis, and drug resistance. PMID: 23810014
- the C-terminal tail of alpha-actinin-4 is essential for its function in cell migration and adhesion to substratum. PMID: 23466492
- results demonstrate that monoclonal C-7 antibody exerts an inhibitory effect on endothelium-dependent vasorelaxation induced by acetylcholine and that this response may at least partially result from the inhibition of alpha-actinin 4 PMID: 23711888
- Actinin-alpha4 readily forms heterodimers composed of monomers that may have different properties and interacting proteins, thus altering our view of non-muscle actinin function. PMID: 23557398
- The tyrosine phosphorylation of alpha-actinin1 at Y12 and alpha-actinin4 at Y265 is critical for dorsal stress fiber establishment, transverse arc maintenance and focal adhesion maturation. PMID: 23454549
- MTBP also inhibited ACTN4-mediated F-actin bundling. PMID: 22370640
- Depletion of alpha-actinin but not RhoA inhibition causes microtubules-cortex associations during early mitosis PMID: 22825873
- In actinin-4-knockdown keratinocytes, focal contact area is increased by 25%, and hemidesmosome proteins are mislocalized. PMID: 23085994
- these results suggest that D5(H) of high molecular weight kininogen may modulate cell adhesion and invasion together with actinin-4. PMID: 23000411
- there is limited evidence of association of the ACTN4 gene in African-Americans with non-diabetic end-stage renal disease PMID: 22965004
顯示更多
收起更多
-
相關疾病:Focal segmental glomerulosclerosis 1 (FSGS1)
-
亞細胞定位:Nucleus. Cytoplasm. Cell junction. Cytoplasm, cytoskeleton, stress fiber. Cytoplasm, perinuclear region.
-
蛋白家族:Alpha-actinin family
-
組織特異性:Widely expressed.
-
數據庫鏈接:
Most popular with customers
-
-
YWHAB Recombinant Monoclonal Antibody
Applications: ELISA, WB, IHC, IF, FC
Species Reactivity: Human, Mouse, Rat
-
Phospho-YAP1 (S127) Recombinant Monoclonal Antibody
Applications: ELISA, WB, IHC
Species Reactivity: Human
-
-
-
-
-